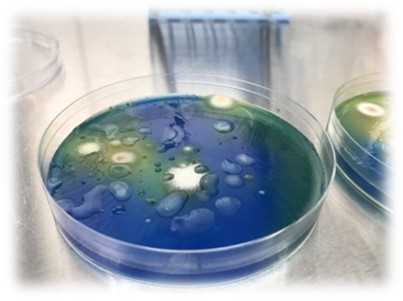
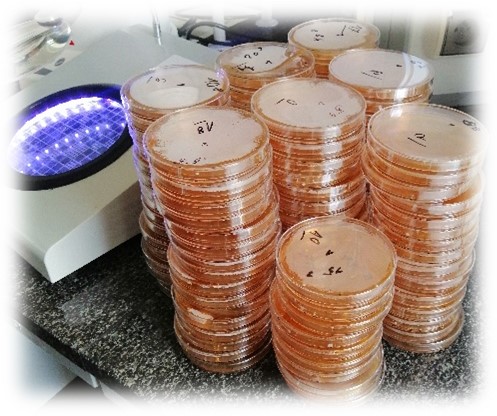
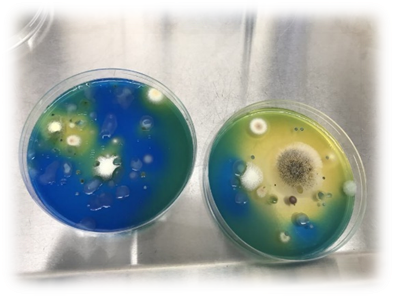

Aktualności/News
Staż naukowo-badawczy doktoranta Szkoły Doktorskiej UR w ramach programu STER NAWA

Na przełomie kwietnia i maja 2024 roku w Słowackim Uniwersytecie Rolniczym w Nitrze staż naukowy odbywał doktorant Szkoły Doktorskiej w Uniwersytecie Rzeszowskim, mgr inż. Kamil Szopa, doktorant IV roku, kształcący się w dyscyplinie: technologia żywności i żywienia. Staż odbywał się w ramach projektu „UR an international PhD student” STER NAWA – umiędzynarodowienie szkół doktorskich.
Pobyt na stażu w Słowackim Uniwersytecie Rolniczym w Nitrze pozwolił na zapoznanie się z zakresem badań i procedurą pracy zagranicznego ośrodka naukowego. Przeprowadzone zostały badania i pozyskano materiały niezbędne do pracy nad rozprawą doktorską. Staż umożliwił także poznanie nowych technik i technologii badawczych oraz wzbogacił warsztat badawczy doktoranta. Stworzył możliwość przeprowadzenia własnych badań z wykorzystaniem metod analizy molekularnej PCR, a także przeprowadzenie identyfikacji mikroflory za pomocą spektrometrii masowej – MALDI-TOF MS (matrix-assisted laser desorption/ionization time-of-flight mass spectrometry) z wykorzystaniem zasobów biblioteki danych niedostępnej w Polsce.
Ważnym aspektem wyjazdu było także poznanie specjalistów-laborantów z zakresu technologii żywności pracujących na tamtejszej Uczelni oraz wymiana doświadczeń, co zaowocowało dalszą współpracą.